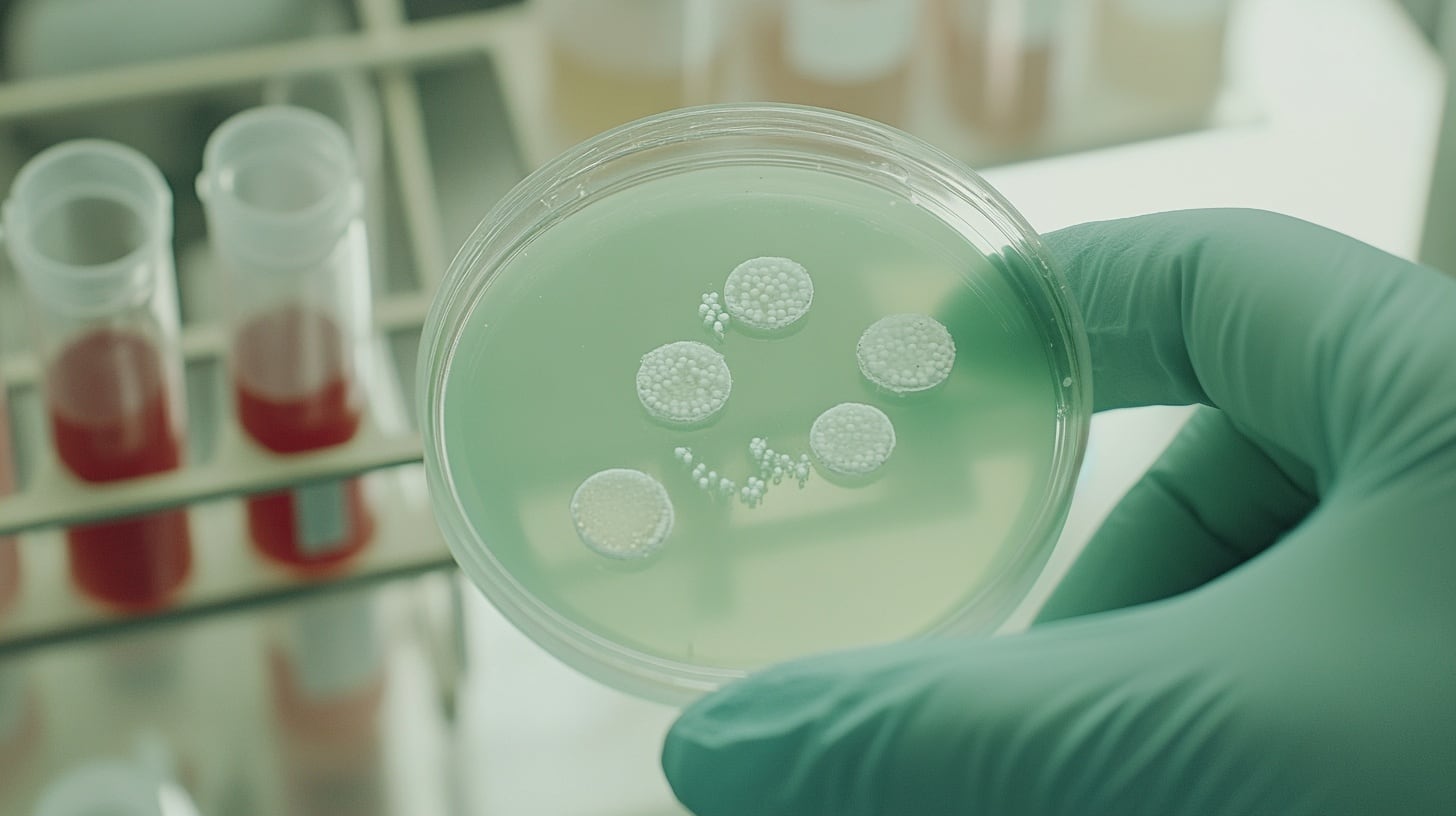
Científicos de la Universidad de Stanford descubrieron una nueva forma de fabricar ADN en bacterias sin necesidad de copiar un molde previo (Imagen Ilustrativa Infobae)

El ADN es la clave que define cómo funciona todo ser vivo, incluyendo los seres humanos. Sus cuatro letras, A, T, G y C, forman la receta para armar y mantener la vida en cada célula.
Este sábado 25 de abril se celebra el Día del ADN para recordar el momento en que los científicos James Watson y Francis Crick describieron la estructura de doble hélice del ADN en la revista Nature.
Eso ocurrió en 1953 y con el paso del tiempo se encontraron indicios de que la investigadora británica Rosalind Franklin fue fundamental en este hallazgo: obtuvo imágenes de difracción de rayos X, especialmente la famosa Foto 51, que permitió ver la forma real del ADN.

Este año, el Día del ADN se llena de emoción con un hallazgo que rompe esquemas. Un grupo de científicos de la Universidad de Stanford, en los Estados Unidos, descubrió que existe una nueva forma de fabricar ADN en bacterias. Este avance cambia lo que se creía posible.
Pujuan Deng, Hyunbin Lee, Carlo Armijo, Haoqing Wang y Alex Gao fueron parte del equipo que publicó el hallazgo en la revista Science.
Sugirieron que las bacterias pueden fabricar ADN de doble cadena sin copiar un molde previo, al usar proteínas especializadas. De esta manera, dieron cuenta de una nueva forma natural de crear ADN.
En diálogo con Infobae, el doctor Gao desde los Estados Unidos explicó: “Lo que más nos sorprendió fue que la proteína Drt3b lograra fabricar una molécula llamada poli(AC). No esperábamos que se pudiera hacer la segunda cadena de ADN para formar la doble hélice de esta manera, hasta que vimos la estructura en el microscopio y todo tuvo sentido». La proteína Drt3b se encuentra dentro de ciertas bacterias.
Enseguida, el científico de Stanford afirmó: “Quiero aclarar que lo que descubrimos no contradice la idea principal de la biología sobre cómo funciona la información genética, aunque algunas personas en internet lo hayan dicho”.
La proteína está hecha solo para fabricar poli(AC) y no sirve para pasar información de aminoácidos a ADN en general.

“Lo que sorprende aquí es que en este caso se logra completar la doble hélice de ADN sin copiar otra cadena que ya existía, pero eso solo pasa en situaciones muy específicas y no cambia las reglas generales de cómo funciona la biología”, subrayó.
El científico especificó entonces que la proteína Drt3b solo funciona en casos muy especiales y no convierte información de proteínas a ADN como se hace en los seres vivos en general.
El misterio del ADN: más allá de las reglas

El ADN es la molécula que almacena toda la información genética. En los libros de biología se enseña que para fabricar ADN nuevo, siempre se copia una cadena ya existente, al usar enzimas llamadas polimerasas. Así se mantiene la fidelidad del código.
Antes de que se realizara el nuevo estudio, los científicos pensaban que todas las polimerasas necesitaban un molde, es decir, una cadena previa de ADN o ARN, para hacer una nueva. En bacterias, el ADN también sirve como defensa contra virus, llamados fagos.
El doctor Gao y sus colegas intentaron saber si existía en la naturaleza una forma de fabricar ADN sin copiar otro ADN o ARN, y si eso tenía algún papel en la defensa bacteriana.
Se preguntaron si alguna proteína podía construir una cadena de ADN con una secuencia exacta, sin depender de un molde previo.
El laboratorio revela sus secretos

Los científicos de Stanford prepararon un experimento con bacterias que tienen el sistema DRT3. Extrajeron las proteínas y el ARN especial de esas bacterias para estudiarlas en detalle.
Colocaron ese sistema en otras células y comprobaron que, con solo estas piezas, se podía fabricar ADN largo y repetitivo. Las letras GT y AC se alternaban como un patrón fijo y perfectamente ordenado.
Usaron microscopía crioelectrónica para observar de cerca la estructura de las proteínas y el ARN. Descubrieron que todo el sistema se organiza como un complejo simétrico, donde cada parte tiene su lugar exacto.
Detectaron que, si alguna proteína o el ARN fallaba, la bacteria ya no podía fabricar este ADN especial. Así, la defensa contra los virus desaparecía y la bacteria quedaba vulnerable.
Los resultados indicaron que la proteína Drt3b puede fabricar una cadena de ADN al usar solo su propia estructura. No necesita copiar ningún molde, algo que nunca se había demostrado en sistemas naturales.

“Aunque todavía es pronto para saber exactamente en qué se va a usar, lo que más nos emociona de DRT3 es que ayuda a entender mejor cómo funciona la creación del ADN”, resaltó el doctor Gao en la entrevista con Infobae.
Además -añadió- demuestra que el mundo de los microbios “guarda un montón de funciones sorprendentes en sus enzimas que aún no hemos descubierto”.
El equipo de investigadores reconoció que todavía no se sabe cómo, exactamente, este ADN repetitivo protege a las bacterias de los virus.
Por eso, consideraron que se debe seguir investigando cómo funciona el mecanismo y si puede tener aplicaciones en medicina o tecnología genética.













